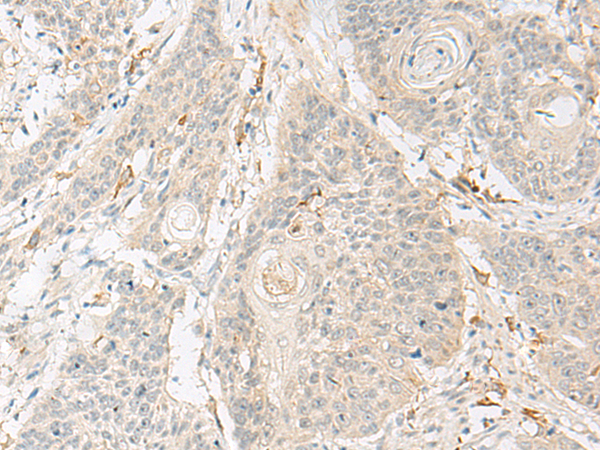
一抗

|
Background: |
Sweet, bitter, and umami tastes are transmitted from taste receptors by a specific guanine nucleotide binding protein. The protein encoded by this gene is the alpha subunit of this heterotrimeric G protein, which is found not only in the oral epithelium but also in gut tissues. Variations in this gene have been linked to metabolic syndrome. |
|
Applications: |
ELISA, IHC |
|
Name of antibody: |
GNAT3 |
|
Immunogen: |
Synthetic peptide of human GNAT3 |
|
Full name: |
G protein subunit alpha transducin 3 |
|
Synonyms: |
GDCA |
|
SwissProt: |
A8MTJ3 |
|
ELISA Recommended dilution: |
5000-10000 |
|
IHC positive control: |
Human thyroid cancer and Human esophagus cancer |
|
IHC Recommend dilution: |
40-200 |


 購物車
購物車 幫助
幫助
 021-54845833/15800441009
021-54845833/15800441009